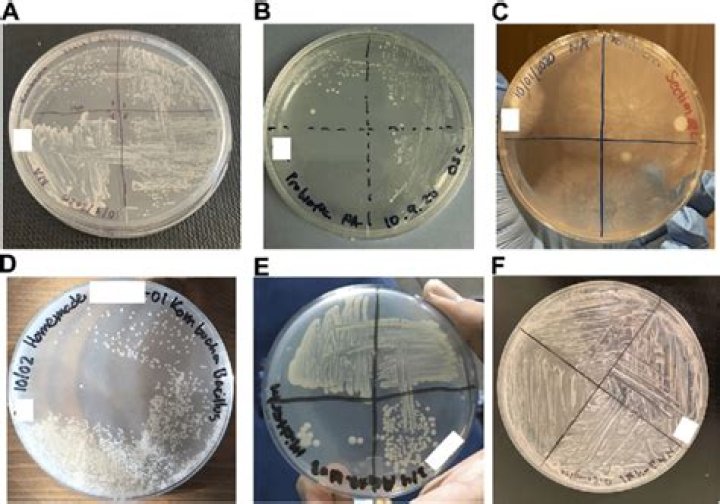

Aspen wood is often used for exterior finish. It is sometin.es used in the rough for this purpose. Rough aspen lumber used on the exterior of a warehouse located near Greaney, Minnesota, was in good condition in 1944 after 19 years of service.
Is Aspen wood weather resistant?
Aspen is moderately resistant to weathering (USDA 1999). Aspen weathers to a light gray color. The weathered wood tends to have moderate sheen. Weathering checks are usually small and inconspicuous.
What wood is best for outdoor weather?
- Acacia. Acacia is a thick, strong hardwood with high oil content. …
- Black Locust. Black Locust is one of the strongest and stiffest domestic woods. …
- Cedar. Cedar is soft, light, and easy to work with. …
- Cypress. …
- Douglas-Fir. …
- Ipe. …
- Redwood. …
- Teak.
Is Aspen a good wood for outdoor furniture?
Is Aspen A Good Wood for Furniture? Aspen is a good wood for furniture that captures a rustic look. It will take stain and paint well, and it sands nicely too. While it accepts most stains well, it can be beneficial to use a sealer.Is Aspen plywood rot resistant?
Aspen wood is white and soft, but fairly strong, and has an even grain. Has a number of uses including sauna interiors, rural construction, furniture and roofing. The dry timber weathers very well, becoming silvery-grey and resistant to rotting and warping.
Do aspens rot?
Aspen trunk rot is the most common stem decay of aspen in North America. It is especially common in the Rocky Mountains and in Colorado. Aspen trunk rot prevalence varies with age and soil conditions. In regions where aspen grow quickly and mature early, decay also advances rapidly and early in the tree’s life.
Is aspen wood good for anything?
The light-colored aspen is frequently used to make cheese containers and baskets and all kinds of crates and boxes. It is an excellent wood for excelsior – wood wool – and for pulp and paper making. It is also used to make brake blocks and for furniture parts and interiors.
Is aspen or pine stronger?
Aspen is harder than Pine. In terms of hardness and density, Aspen wood is a hardwood and Pinewood is a softwood. So, most of the times hardwoods have higher hardness and strength than softwoods.Is aspen easy to stain?
Aspen does not split when nailed, it machines easily with a slightly fuzzy surface, and turns, bores, and sands well. It takes paint and stain well to produce a good finish, although care is required where the surface is fuzzy.
Can any wood be used outside?In general, any wood will work for an outdoor project if it’s kept dry and regularly maintained However, some woods do have a higher resistance to decay than others.
Article first time published onWhat is the most rot resistant wood?
- Cedar. Cedar is one of the best woods all-around. …
- Redwood. Redwood is one of the most popular rot-resistant woods for building houses. …
- Mesquite. …
- Mahogany. …
- Yew. …
- Bald Cypress. …
- Black Walnut. …
- White Oak.
What types of wood are water resistant?
- Redwood and Cedar. There is a good reason a lot of popular deck builders prefer to use redwood or red cedar. …
- Pressure-Treated Lumber. …
- Composite. …
- Tropical hardwood.
How strong is Aspen?
Aspen is quite weak, being half as strong, or less, than red oak. The bending strength (MOR) is 8400 psi and the elasticity is 1.2 million psi. The hardness is only 350 pounds. Nevertheless, aspen is still strong enough to be used for studs in home building, pallets, and some other structural uses.
Is Aspen a hardwood or softwood?
(Populus tremoloides) Although aspen is a hardwood species, it is offered by the majority of softwood manufacturers. Aspen has creamy white sapwood with heartwood that changes from brown to greyish white without any visible transition.
Is Aspen wood easy to carve?
Aspen is another white wood that is quite popular among woodworkers. It’s stronger than basswood but is still quite soft, so it is fairly easy to use for carving. Aspen is readily available and inexpensive. Butternut is another good wood for beginner wood carving.
Is aspen a good firewood?
Quaking aspen firewood only produces about half the heat as other hardwoods such as oak. It’s not the best of choice for firewood but if you can buy it cheap or get it free you might as well burn it. Quaking aspen can make decent campfire wood and is often straight grained and easy to split.
What are aspens good for?
Aspen provide habitat for a wide variety of wildlife, including hare, moose, black bear, elk, deer, ruffed grouse, migratory birds, and a variety of smaller animals. Aspen stands produce livestock forage, biomass, and are a source for a variety of wood products.
What can aspen be used for?
Aspen is a tree. The bark and leaf of the tree are used to make medicine. Aspen is used in combination with other herbs for treating joint pain (rheumatism), prostate discomforts, back trouble (sciatica), nerve pain (neuralgia), and bladder problems.
How do you treat aspen cankers?
It is one of the most destructive diseases to aspens in forests and in the home landscape. To manage this disease, prune out dead or dying branches before the infection reaches that main trunk. Remove weak trees that have cankers on the main trunk. These trees often break in the wind.
What fungus grows on aspen trees?
Marssonina Blight The Marssonina fungus causes this most common disease on aspen foliage. Although there is leaf discoloration, this condition usually is not damaging. Heavy infestations cause early leaf drop.
What is killing my aspen tree?
Aspens are affected by a variety of fungal problems that affect the foliage, including leaf spot, aspen leaf blight, and rust. Most of these diseases can defoliate the tree. … Another common aspen tree problem is cytospora canker.
What's the difference between aspen and Poplar?
Quaking aspen has smaller heart-shaped to circular (orbicular) leaves with fine (serrate) teeth on the edges. Balsam poplar leaves are quite variable across its range but in general they are egg-shaped (ovate) or more narrowly spear-shaped (lanceolate) with very small teeth along the leaf margin.
Is aspen good for shelving?
Aspen is a type of wood that is sometimes used in the construction of inexpensive cabinets. This is a softer wood, which means it requires larger and more fasteners. … It is not recommended to use Aspen in the construction of load-bearing frames, shelves or drawers due to its low level of strength.
Is aspen an evergreen?
About Aspen (Populus tremuloides) Probably the most popular tree for the Evergreen, CO area, aspen, also called quaking aspen, are beloved for their distinctive sound and fall color.
Can you sand aspen wood?
Aspen is an interesting wood to work with because of its natural softness. Even with sharp cutting tools, the wood tends to tear rather than cut. This tearing can make sanding extensive. I have found it more effective to stop short of my final turning diameter on the lathe and sand by hand the rest of the way.
How soft is aspen wood?
Hardwood species are defined as being deciduous; they lose their leaves seasonally. So, their hardness can vary. Getting back to aspen, it scores a pretty low 420 on the Janka Hardness Scale. That’s even softer than Douglas fir, which is a softwood (and therefore doesn’t lose its leaves seasonally – you get the idea).
Can you paint Aspen plywood?
Suitable for paint, high-pressure laminate, veneer or other specialty surface treatments.
How do you make cheap wood last outside?
- Use linseed or Tung oil to create a beautiful and protective hand-rubbed finish.
- Seal the wood with coating of polyurethane, varnish, or lacquer.
- Finish and waterproof wood simultaneously with a stain-sealant combo.
How long will treated wood last outside?
How Long Does Pressure Treated Wood Last Outside? The lifespan of the pressure-treated wood exposed outside is 40 years. This is the standard lifespan for treated wood.
How do you keep wood from rotting?
You’ll first have to dry the wood by repairing leaks and/or running a dehumidifier. Once the wood is dry, you can apply a wood preservative that contains copper or borate, such as Woodlife Copper Coat Wood Preservative (available on Amazon). Monitor the wood because it’s still at an increased risk of future rot.
What kind of wood should I use for a front porch?
While natural fir is the traditional choice for a porch floor, good wood alternatives include cedar, mahogany and Brazilian Ipe. You can add interest and texture to your porch floor by mixing woods or laying boards in a creative pattern.